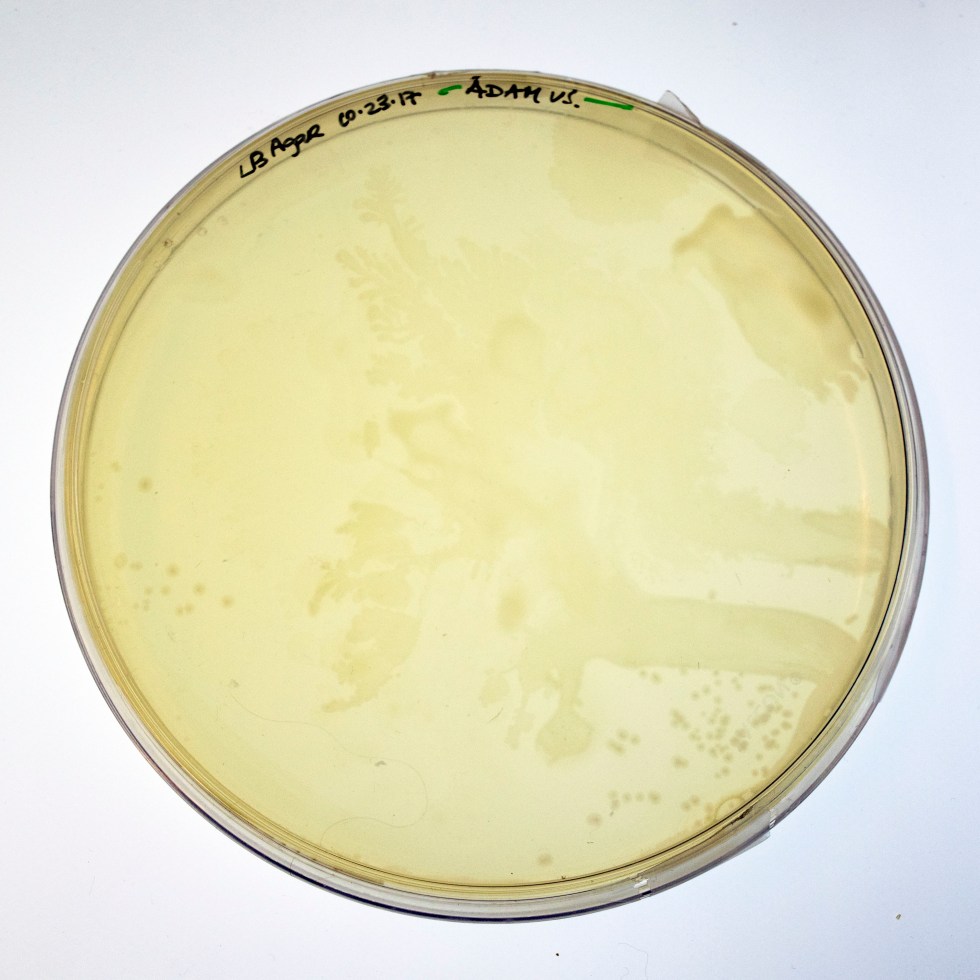
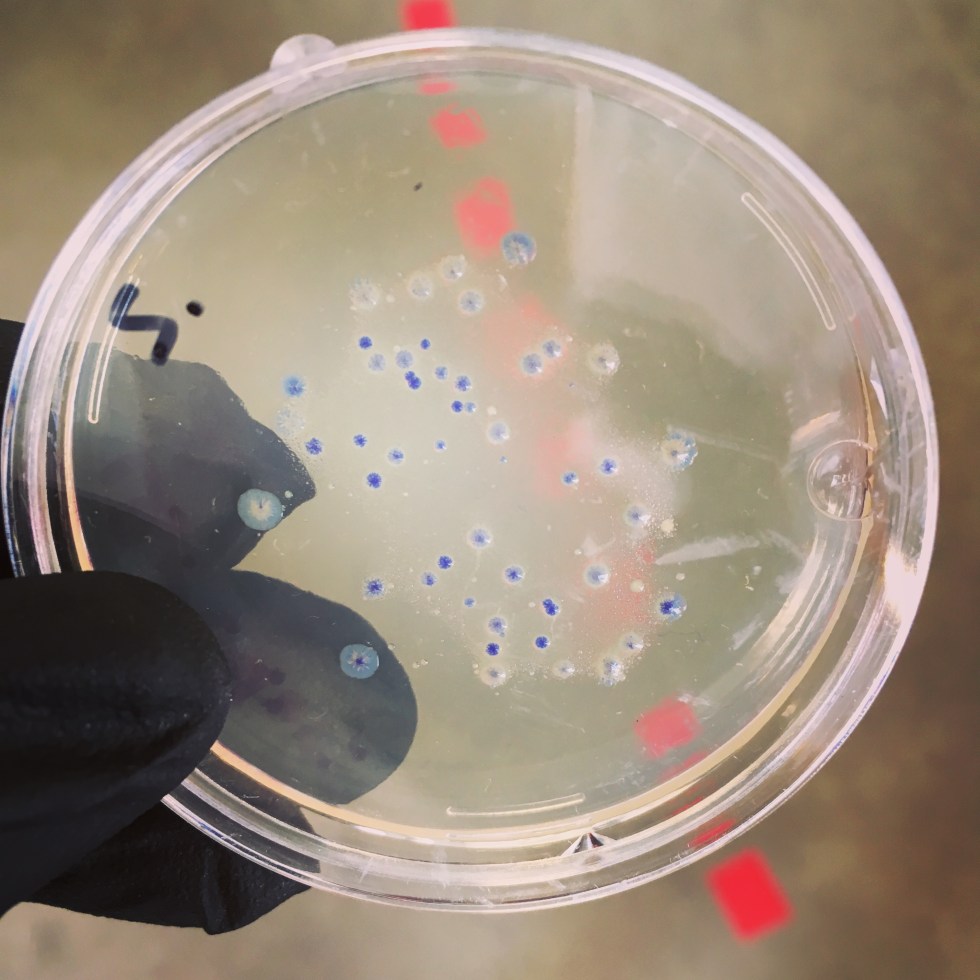

Category: workshops

Luminous and Colourful Microbial Cultures workshop

Imagining Microscopy workshop at Milieux
Bacterial BioPigments – GMO play, from DNA to CMYK! MilieuxMake Summer Atelier with WhiteFeather and Marc Beaulieu

WhiteFeather co-teaches Intro to E-textiles workshop with Joanna Berzowska

Vernissage et exposition d’Arts médiatiques en famille 2017

WhiteFeather co-teaches Bioart Fun with Physarum at Studio XX, Montreal

Do-it-Together Incubator workshop, Milieux Institute

